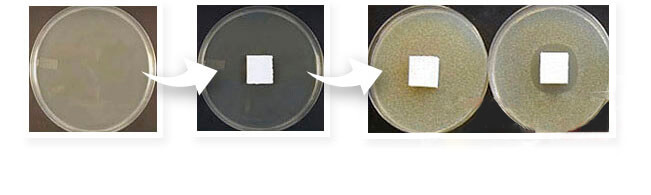

Gube so kožni pregibi, ki se pojavijo na vašem obrazu, vratu, rokah in drugih delih telesa. So posledica trganja in poškodb prožnih vezivnih vlaken kot sta kolagen in elastin, ki sta dve najpomembnejši sestavini človeške kože.
Na nastajanje gub, ki se pojavijo na človeški koži, vplivajo številni zunanji dejavniki, kot so dolgotrajna izpostavljenost soncu in vetru, nihanje temperatur zraka, pretirana suhost in pretirana vlažnost zraka. Če si prizadevate za ohranitev mladostnega videza vaše kože, ji morate zagotavljati pravilno nego. Nepremišljena izbira kozmetičnih izdelkov in opustitev vsakršne nege kože lahko nanjo negativno vplivata.

Izdelki, ki se običajno uporabljajo za preprečevanje in odpravljanje gub, vplivajo le na njihov zunanji izgled. Goji Cream pa, v nasprotju z njimi, temelji na izboljšani tehnologiji, ki zdravilnim komponentam omogoča prodiranje globoko v kožne plasti, omogoča odpravljanje sprememb, povezanih s starostjo ter spodbuja proces pomlajevanja in regeneracije kože, ki je ključen za ohranjanje mladostnega videza.
Gube so lahko tudi posledica oslabljenega imunskega sistema, klimatskih sprememb, vpliva UV žarkov, naravnega staranja telesa, dehidracije kože, uporabe neustreznih kozmetičnih sredstev in nepravilnega čiščenja kože. Goji Cream odstrani vse gubice, ne glede na razlog njihovega nastanka in odpravi težavo enkrat za vselej.
Izdelek vsebuje različne sestavine, ki kožo ščiotijo pred UV žarki in ji vračajo biološko aktivne snovi, ki so odgovorne za obnavljanje celične strukture.
S spodbujanjem naravne tvorbe kolagena v globokih plasteh kože Goji Cream v čratkem času pripomore k obnavljanju prožnosti in mladostnega videza kože!
Vašo kožo je potrebno vlažiti brez mašenja por in brez sprožanja neželenega delovanja kožnih žlez. Goji Cream ne blokira dostopa kisika do celic kože in izboljša mikrocirkulacijo teh območij.
Kombinacija čiščenja, vlaženja in toniranja, ki jo zagotavljajo zdravilne sestavine, nahrani kožo, poskrbi za uravnovešeno delovanje oljnih žlez in prepreči dehidracijo kože.

Krema pomaga pri preprečevanju ponovnega nastajanja gub, saj kožo vašega obraza in vratu obogati s širokim spektrom vitaminov, mikroelementov in amino kislin.


Običajno uporabljeni izdelki za glajenje kože delujejo le na površinski del kože in so torej v primerjavi z Goji Cremo dokaj neučinkoviti.
Goji Cream prodre v globoke plasti kože, odstrani starostne spremembe in pripomore k procesu obnavljanja celic kože na obrazu.
Goji Cream hitro deluje na kožo, ki je izgubila svojo prožnost. Po njeni uporabi se koža ne sveti, žari od znotraj, pridobi naraven videz, je navlažena, čvrsta, sproščena in brez gub.
Nova cena: 39 €